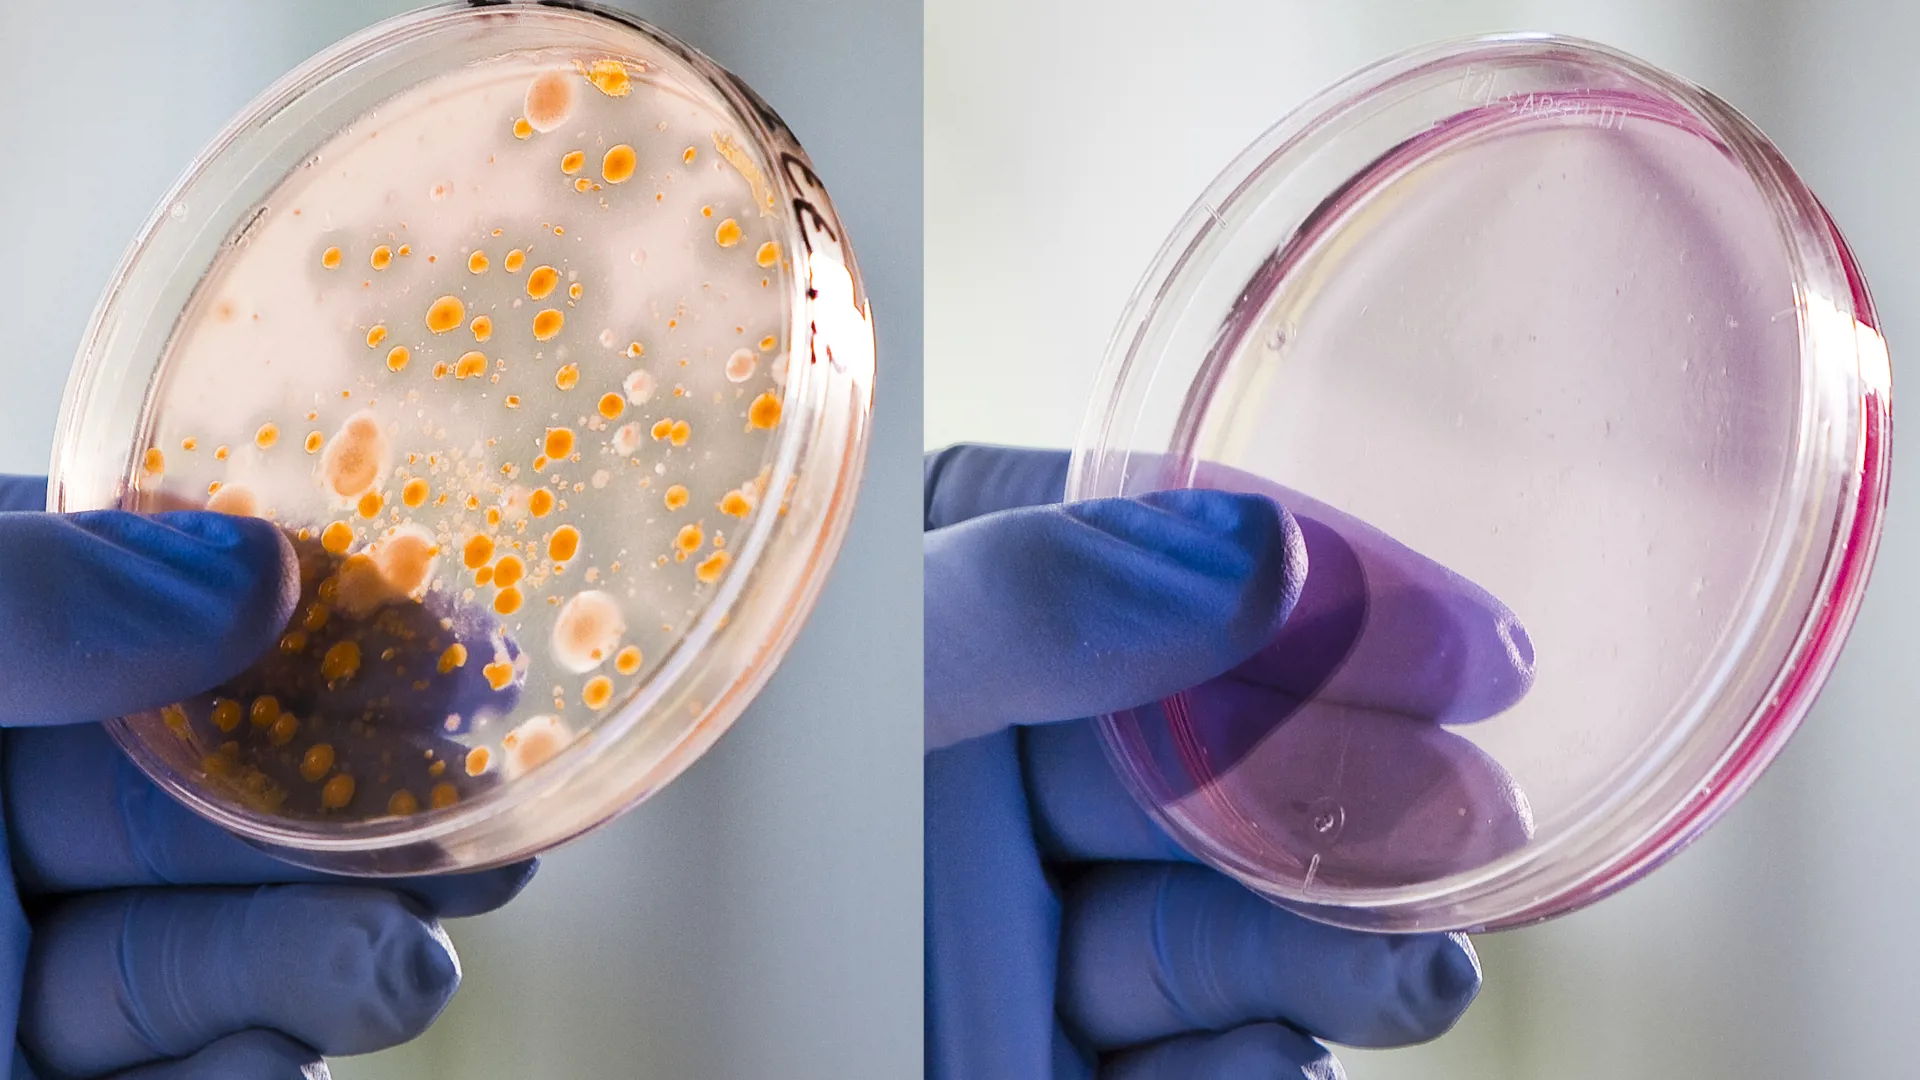
Comparison of bacterial growth after standard pasteurization versus SANOVO WAVE Technology.

Not sure whether your product is ready for pasteurization / sterilization with Ohmic heating?
Before the actual test is conducted we carry out a a pre-examination of your product.
This is a visual inspection of your product to evaluated if it can be pasteurized or not.